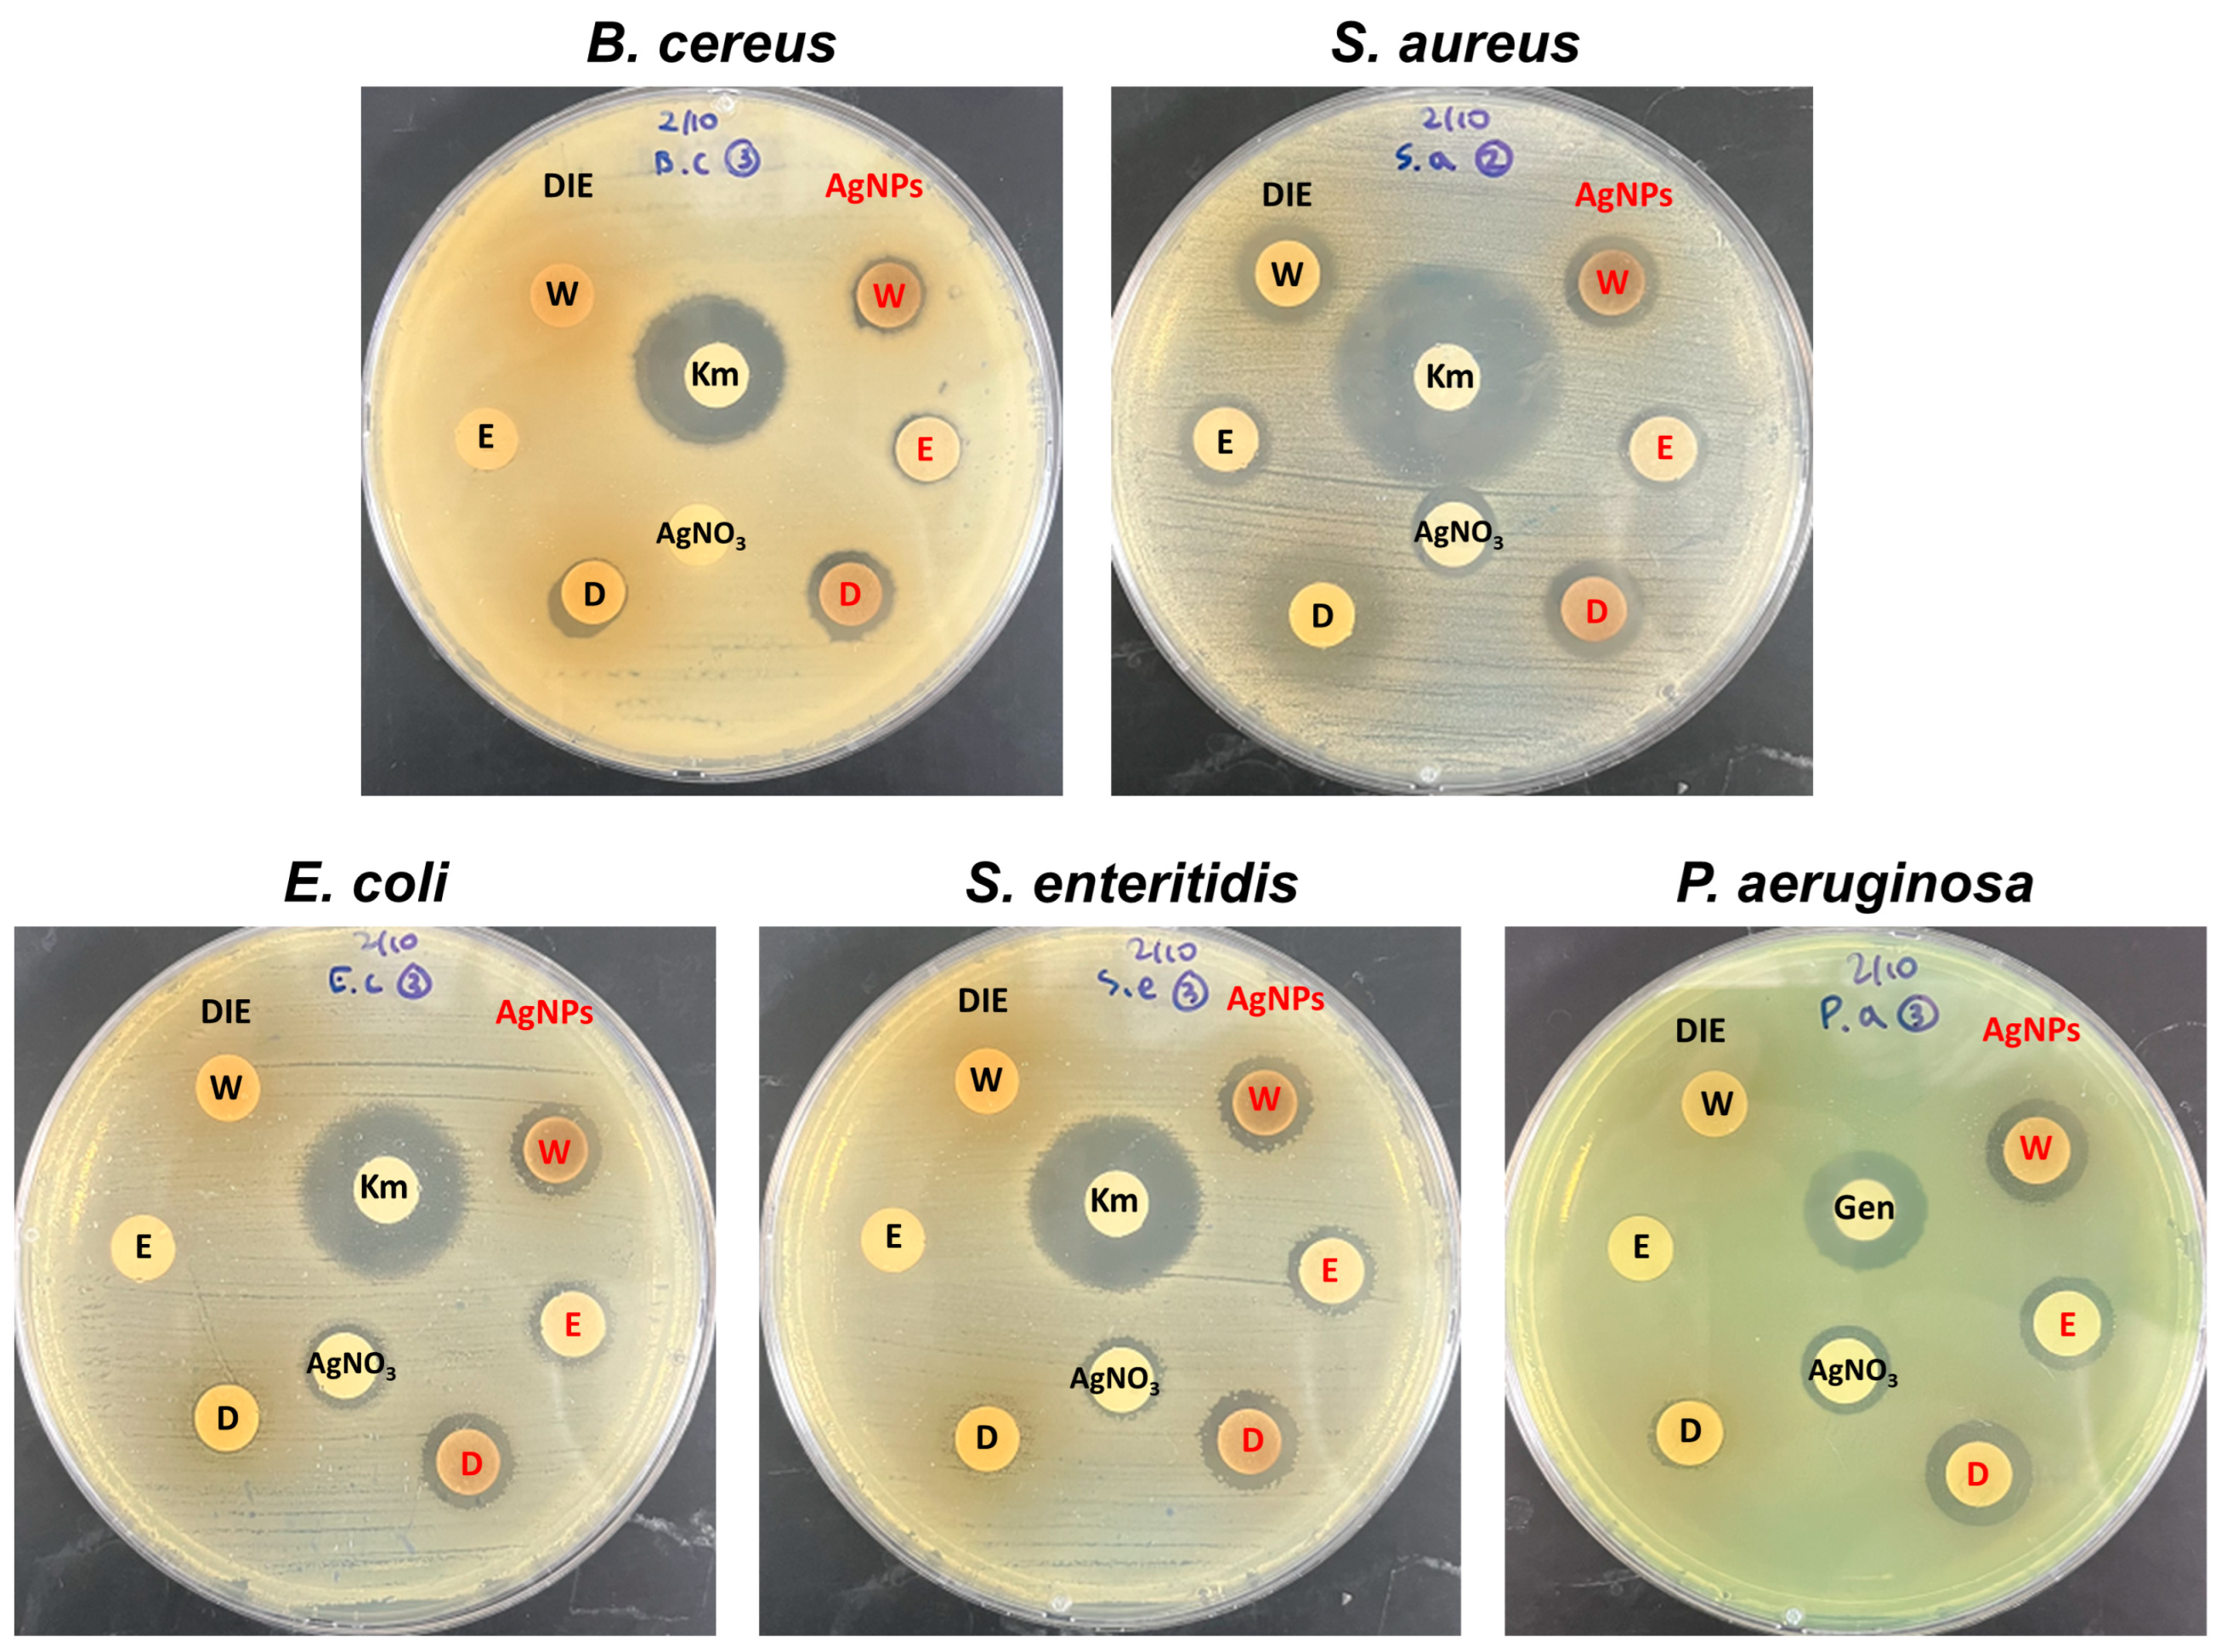
Microorganisms 11 01539 g005 Microorganisms 11 01539 g005

Biosynthesis of Silver Nanoparticles from Duchesnea indica Extracts Using Different Solvents and Their Antibacterial Activity
Abstract
1. Introduction
2. Materials and Methods
2.1. Materials
2.2. Preparation of Duchesnea Indica Extracts
2.3. AgNP Biosynthesis and Characterization
2.4. Antibacterial Activity
2.5. Determination of Minimum Inhibitory Concentration (MIC) and Minimum Bactericidal Concentration (MBC)
3. Results and Discussion
3.1. Biosynthesis of AgNPs Using Different Solvent-Assisted Extracts
3.2. Characterization of Biosynthesized AgNPs
3.3. Antibacterial Activity of Biosynthesized AgNPs
3.4. Determination of Minimum Inhibitory Concentration (MIC) and Minimum Bactericidal Concentration (MBC)
4. Conclusions
Author Contributions
Funding
Data Availability Statement
Conflicts of Interest
References
- Berger, C.N.; Sodha, S.V.; Shaw, R.K.; Griffin, P.M.; Pink, D.; Hand, P.; Frankel, G. Fresh fruit and vegetables as vehicles for the transmission of human pathogens. Env. Microbiol. 2010, 12, 2385–2397. [Google Scholar] [CrossRef] [PubMed]
- Balali, G.I.; Yar, D.D.; Afua Dela, V.G.; Adjei-Kusi, P. Microbial contamination, an increasing threat to the consumption of fresh fruits and vegetables in today’s world. Int. Microbiol. 2020, 2020, 3029295. [Google Scholar] [CrossRef] [PubMed]
- Lee, S.; Han, A.; Yoon, J.-H.; Lee, S.-Y. Growth evaluation of Escherichia coli O157: H7, Salmonella typhimurium, and Listeria monocytogenes in fresh fruit and vegetable juices via predictive modeling. LWT 2022, 162, 113485. [Google Scholar] [CrossRef]
- Duncan, T.V. Applications of nanotechnology in food packaging and food safety: Barrier materials, antimicrobials and sensors. J. Colloid Interface Sci. 2011, 363, 1–24. [Google Scholar]
- Krishnaraj, C.; Jagan, E.; Rajasekar, S.; Selvakumar, P.; Kalaichelvan, P.; Mohan, N. Synthesis of silver nanoparticles using Acalypha indica leaf extracts and its antibacterial activity against water borne pathogens. Colloids Surf. B Biointerfaces 2010, 76, 50–56. [Google Scholar] [CrossRef]
- Kamli, M.R.; Alzahrani, E.A.; Albukhari, S.M.; Ahmad, A.; Sabir, J.S.; Malik, M.A. Combination effect of novel bimetallic Ag-Ni nanoparticles with fluconazole against Candida albicans. J. Fungi 2022, 8, 733. [Google Scholar] [CrossRef]
- Albeladi, S.S.R.; Malik, M.A.; Al-thabaiti, S.A. Facile biofabrication of silver nanoparticles using Salvia officinalis leaf extract and its catalytic activity towards Congo red dye degradation. J. Mater. Res. Technol. 2020, 9, 10031–10044. [Google Scholar] [CrossRef]
- Zhang, X.F.; Liu, Z.G.; Shen, W.; Gurunathan, S. Silver nanoparticles: Synthesis, characterization, properties, applications, and therapeutic approaches. Int. J. Mol. Sci. 2016, 17, 1534. [Google Scholar] [CrossRef]
- Kamli, M.R.; Srivastava, V.; Hajrah, N.H.; Sabir, J.S.; Ali, A.; Malik, M.A.; Ahmad, A. Phytogenic fabrication of Ag–Fe Bimetallic nanoparticles for cell cycle arrest and apoptosis signaling pathways in Candida auris by generating oxidative stress. Antioxidants 2021, 10, 182. [Google Scholar]
- Loo, Y.Y.; Rukayadi, Y.; Nor-Khaizura, M.-A.-R.; Kuan, C.H.; Chieng, B.W.; Nishibuchi, M.; Radu, S. In vitro antimicrobial activity of green synthesized silver nanoparticles against selected gram-negative foodborne pathogens. Front. Microbiol. 2018, 9, 1555. [Google Scholar] [CrossRef]
- Yan, X.; He, B.; Liu, L.; Qu, G.; Shi, J.; Hu, L.; Jiang, G. Antibacterial mechanism of silver nanoparticles in Pseudomonas aeruginosa: Proteomics approach. Metallomics 2018, 10, 557–564. [Google Scholar] [CrossRef] [PubMed]
- Li, W.-R.; Xie, X.-B.; Shi, Q.-S.; Zeng, H.-Y.; Ou-Yang, Y.-S.; Chen, Y.-B. Antibacterial activity and mechanism of silver nanoparticles on Escherichia coli. Appl. Microbiol. Biotechnol. 2010, 85, 1115–1122. [Google Scholar] [CrossRef] [PubMed]
- Lok, C.-N.; Ho, C.-M.; Chen, R.; He, Q.-Y.; Yu, W.-Y.; Sun, H.; Tam, P.K.-H.; Chiu, J.-F.; Che, C.-M. Silver nanoparticles: Partial oxidation and antibacterial activities. J. Biol. Inorg. Chem. 2007, 12, 527–534. [Google Scholar] [PubMed]
- Xiu, Z.-M.; Zhang, Q.-B.; Puppala, H.L.; Colvin, V.L.; Alvarez, P.J. Negligible particle-specific antibacterial activity of silver nanoparticles. Nano Lett. 2012, 12, 4271–4275. [Google Scholar]
- De Moura, M.R.; Mattoso, L.H.; Zucolotto, V. Development of cellulose-based bactericidal nanocomposites containing silver nanoparticles and their use as active food packaging. J. Food Eng. 2012, 109, 520–524. [Google Scholar] [CrossRef]
- Kumar, S.; Shukla, A.; Baul, P.P.; Mitra, A.; Halder, D. Biodegradable hybrid nanocomposites of chitosan/gelatin and silver nanoparticles for active food packaging applications. Food Packag. Shelf Life 2018, 16, 178–184. [Google Scholar]
- Alsammarraie, F.K.; Wang, W.; Zhou, P.; Mustapha, A.; Lin, M. Green synthesis of silver nanoparticles using turmeric extracts and investigation of their antibacterial activities. Colloids Surf. B Biointerfaces 2018, 171, 398–405. [Google Scholar] [CrossRef]
- Yu, D.-G. Formation of colloidal silver nanoparticles stabilized by Na+–poly (γ-glutamic acid)–silver nitrate complex via chemical reduction process. Colloids Surf. B Biointerfaces 2007, 59, 171–178. [Google Scholar] [CrossRef]
- Das, R.; Nath, S.S.; Chakdar, D.; Gope, G.; Bhattacharjee, R. Synthesis of silver nanoparticles and their optical properties. J. Exp. Nanosci. 2010, 5, 357–362. [Google Scholar]
- Iravani, S.; Korbekandi, H.; Mirmohammadi, S.V.; Zolfaghari, B. Synthesis of silver nanoparticles: Chemical, physical and biological methods. Res. Pharm. Sci. 2014, 9, 385. [Google Scholar]
- Firdhouse, M.J.; Lalitha, P. Biosynthesis of silver nanoparticles and its applications. J. Nanotechnol. 2015, 2015, 829526. [Google Scholar] [CrossRef]
- Ahmed, S.; Ahmad, M.; Swami, B.L.; Ikram, S. A review on plants extract mediated synthesis of silver nanoparticles for antimicrobial applications: A green expertise. J. Adv. Res. 2016, 7, 17–28. [Google Scholar] [CrossRef] [PubMed]
- Haggag, E.G.; Elshamy, A.M.; Rabeh, M.A.; Gabr, N.M.; Salem, M.; Youssif, K.A.; Samir, A.; Muhsinah, A.B.; Alsayari, A.; Abdelmohsen, U.R. Antiviral potential of green synthesized silver nanoparticles of Lampranthus coccineus and Malephora lutea. Int. J. Nanomed. 2019, 14, 6217. [Google Scholar] [CrossRef]
- Mohamed, N.; Madian, N.G. Evaluation of the mechanical, physical and antimicrobial properties of chitosan thin films doped with greenly synthesized silver nanoparticles. Mater. Today Commun. 2020, 25, 101372. [Google Scholar] [CrossRef]
- Yousaf, H.; Mehmood, A.; Ahmad, K.S.; Raffi, M. Green synthesis of silver nanoparticles and their applications as an alternative antibacterial and antioxidant agents. Mater. Sci. Eng. C 2020, 112, 110901. [Google Scholar] [CrossRef] [PubMed]
- Liaqat, M.; Kakar, I.U.; Akram, M.; Hussain, S.; Kakar, M.U.; Ahmad, N.; Faryal, R. Antimicrobial and Phytochemical exploration of Duchesnea indica plant. Plant Cell Biotechnol. Mol. Biol. 2021, 22, 74–85. [Google Scholar]
- Zhu, M.; Dong, X.; Guo, M. Phenolic profiling of Duchesnea indica combining macroporous resin chromatography (MRC) with HPLC-ESI-MS/MS and ESI-IT-MS. Molecules 2015, 20, 22463–22475. [Google Scholar] [CrossRef]
- Ilahi, I.; Khuda, F.; Sahibzada, M.U.K.; Alghamdi, S.; Ullah, R.; Dablool, A.S.; Alam, M.; Khan, A.; Khalil, A.A.K. Synthesis of silver nanoparticles using root extract of Duchesnea indica and assessment of its biological activities. Arab. J. Chem. 2021, 14, 103110. [Google Scholar] [CrossRef]
- Anjum, S.; Jacob, G.; Gupta, B. Investigation of the herbal synthesis of silver nanoparticles using Cinnamon zeylanicum extract. Emergent Mater. 2019, 2, 113–122. [Google Scholar] [CrossRef]
- Iloki-Assanga, S.B.; Lewis-Luján, L.M.; Lara-Espinoza, C.L.; Gil-Salido, A.A.; Fernandez-Angulo, D.; Rubio-Pino, J.L.; Haines, D.D. Solvent effects on phytochemical constituent profiles and antioxidant activities, using four different extraction formulations for analysis of Bucida buceras L. and Phoradendron californicum. BMC Res. Notes 2015, 8, 396. [Google Scholar] [CrossRef]
- Dirar, A.; Alsaadi, D.; Wada, M.; Mohamed, M.; Watanabe, T.; Devkota, H. Effects of extraction solvents on total phenolic and flavonoid contents and biological activities of extracts from Sudanese medicinal plants. S. Afr. J. Bot. 2019, 120, 261–267. [Google Scholar] [CrossRef]
- Kokkali, M.; Martí-Quijal, F.J.; Taroncher, M.; Ruiz, M.-J.; Kousoulaki, K.; Barba, F. Improved extraction efficiency of antioxidant bioactive compounds from Tetraselmis chuii and Phaedoactylum tricornutum using pulsed electric fields. Molecules 2020, 25, 3921. [Google Scholar] [CrossRef] [PubMed]
- Huo, C.; Hao, Z.; Yuan, C.; Chen, Y.; Liu, J. Probing the Phytosynthesis Mechanism of Gold and Silver Nanoparticles by Sequential Separation of Plant Extract and Molecular Characterization with Ultra-High-Resolution Mass Spectrometry. ACS Sustain. Chem. Eng. 2022, 10, 3829–3838. [Google Scholar] [CrossRef]
- Barbhuiya, R.I.; Singha, P.; Asaithambi, N.; Singh, S.K. Ultrasound-assisted rapid biological synthesis and characterization of silver nanoparticles using pomelo peel waste. Food Chem. 2022, 385, 132602. [Google Scholar] [CrossRef] [PubMed]
- Iravani, S.; Zolfaghari, B. Green synthesis of silver nanoparticles using Pinus eldarica bark extract. BioMed. Res. Int. 2013, 2013, 639725. [Google Scholar] [CrossRef]
- Zuorro, A.; Iannone, A.; Natali, S.; Lavecchia, R. Green synthesis of silver nanoparticles using bilberry and red currant waste extracts. Processes 2019, 7, 193. [Google Scholar] [CrossRef]
- Oliveira, A.E.F.; Pereira, A.C.; de Resende, M.A.C.; Ferreira, L.F. Synthesis of a silver nanoparticle ink for fabrication of reference electrodes. Talanta Open 2022, 5, 100085. [Google Scholar] [CrossRef]
- Vanaja, M.; Annadurai, G. Coleus aromaticus leaf extract mediated synthesis of silver nanoparticles and its bactericidal activity. Appl. Nanosci. 2013, 3, 217–223. [Google Scholar] [CrossRef]
- Lee, Y.Y.; Yuk, H.J.; Saba, E.; Kim, S.D.; Kim, D.-S.; Kopalli, S.R.; Oh, J.-W.; Rhee, M.H. Duchesnea indica Extract Ameliorates LPS-Induced Septic Shock in Mice. eCAM 2022, 2022, 5783867. [Google Scholar] [CrossRef]
- Kang, J.; Lee, J.; Hyun, E.; Lee, E.; Lee, S.; Lee, D.; Lee, N.; Hyun, C. Potential cosmeceutical applications of a water extract of Duchesnea indica cultivated in Jeju Island. Der. Pharma. Chem. 2016, 8, 39–48. [Google Scholar]
- Feng, D.; Zhang, R.; Zhang, M.; Fang, A.; Shi, F. Synthesis of Eco-Friendly Silver Nanoparticles Using Glycyrrhizin and Evaluation of Their Antibacterial Ability. Nanomaterials 2022, 12, 2636. [Google Scholar] [CrossRef] [PubMed]
- Elemike, E.E.; Onwudiwe, D.C.; Ekennia, A.C.; Ehiri, R.C.; Nnaji, N. Phytosynthesis of silver nanoparticles using aqueous leaf extracts of Lippia citriodora: Antimicrobial, larvicidal and photocatalytic evaluations. Mater. Sci. Eng. C 2017, 75, 980–989. [Google Scholar] [CrossRef] [PubMed]
- Tang, S.; Zheng, J. Antibacterial activity of silver nanoparticles: Structural effects. Adv. Healthc. Mater. 2018, 7, 1701503. [Google Scholar] [CrossRef]
- Raza, M.A.; Kanwal, Z.; Rauf, A.; Sabri, A.N.; Riaz, S.; Naseem, S. Size-and shape-dependent antibacterial studies of silver nanoparticles synthesized by wet chemical routes. Nanomaterials 2016, 6, 74. [Google Scholar] [CrossRef] [PubMed]

| AgNP Sample | Zeta Potential (mV) | Peak 1 (nm) | Peak 2 (nm) |
|---|---|---|---|
| Distilled water extract | −22.0 ± 0.3 | 266.9 ± 287.4 | 21.4 ± 6.4 |
| Ethanol extract | −19.3 ± 0.2 | 76.4 ± 47.5 | 9.8 ± 3.6 |
| DMSO extract | −19.0 ± 0.6 | 78.2 ± 31.2 | - |
| Sample | Bacteria | B. cereus | S. aureus | E. coli | S. enteritidis | P. aeruginosa |
|---|---|---|---|---|---|---|
| Solvent | Zone of Inhibition (mm) | |||||
| Duchesnea indica extract | Water | NA | 12.26 ± 0.19 | NA | NA | NA |
| EtOH | NA | 11.39 ± 0.05 | NA | NA | NA | |
| DMSO | 9.69 ± 0.23 | 14.92 ± 0.42 | 8.52 ± 0.44 | 8.82 ± 0.04 | 8.87 ± 0.08 | |
| AgNPs | Water | 9.30 ± 0.11 | 11.64 ± 0.32 | 11.35 ± 0.09 | 11.20 ± 0.45 | 12.53 ± 0.13 |
| EtOH | 9.04 ± 0.10 | 10.82 ± 0.29 | 10.90 ± 0.13 | 10.47 ± 0.27 | 11.57 ± 0.03 | |
| DMSO | 10.70 ± 0.22 | 12.86 ± 0.34 | 12.20 ± 0.21 | 11.75 ± 0.29 | 12.98 ± 0.12 | |
| AgNO3 | 8.23 ± 0.25 | 10.87 ± 0.14 | 10.12 ± 0.04 | 10.17 ± 0.39 | 11.23 ± 0.16 | |
| Antibiotics | 18.95 ± 0.45 | 27.88 ± 0.49 | 22.60 ± 0.76 | 21.07 ± 0.46 | 15.96 ± 0.23 | |
| Bacteria | |||||||||||
|---|---|---|---|---|---|---|---|---|---|---|---|
| B. cereus | S. aureus | S. enteritidis | E. coli | P. aeruginosa | |||||||
| Samples | Solvent | MIC | MBC | MIC | MBC | MIC | MBC | MIC | MBC | MIC | MBC |
| Duchesnea indica extract (mg/mL) | Water | >5 | >5 | >5 | >5 | >5 | >5 | >5 | >5 | >5 | >5 |
| EtOH | 2.5 | 5 | 5 | >5 | >5 | >5 | >5 | >5 | >5 | >5 | |
| DMSO | 1.25 | 2.5 | 2.5 | 5 | 5 | 5 | 2.5 | 5 | 2.5 | 5 | |
| AgNPs (mg/mL) | Water | 0.5 | 0.5 | 1 | >1 | 0.5 | 0.5 | 0.5 | 0.5 | 0.25 | 0.5 |
| EtOH | 0.5 | 1 | >1 | >1 | >1 | 1 | 1 | 1 | 1 | 1 | |
| DMSO | 0.25 | 0.25 | 1 | >1 | 0.25 | 0.5 | 0.25 | 0.5 | 0.25 | 0.5 | |
Disclaimer/Publisher’s Note: The statements, opinions and data contained in all publications are solely those of the individual author(s) and contributor(s) and not of MDPI and/or the editor(s). MDPI and/or the editor(s) disclaim responsibility for any injury to people or property resulting from any ideas, methods, instructions or products referred to in the content. |
© 2023 by the authors. Licensee MDPI, Basel, Switzerland. This article is an open access article distributed under the terms and conditions of the Creative Commons Attribution (CC BY) license (https://creativecommons.org/licenses/by/4.0/).
Share and Cite
Kim, S.-M.; Choi, H.-J.; Lim, J.-A.; Woo, M.-A.; Chang, H.-J.; Lee, N.; Lim, M.-C. Biosynthesis of Silver Nanoparticles from Duchesnea indica Extracts Using Different Solvents and Their Antibacterial Activity. Microorganisms 2023, 11, 1539. https://doi.org/10.3390/microorganisms11061539
Kim S-M, Choi H-J, Lim J-A, Woo M-A, Chang H-J, Lee N, Lim M-C. Biosynthesis of Silver Nanoparticles from Duchesnea indica Extracts Using Different Solvents and Their Antibacterial Activity. Microorganisms. 2023; 11(6):1539. https://doi.org/10.3390/microorganisms11061539
Chicago/Turabian StyleKim, Se-Min, Hye-Jo Choi, Jeong-A Lim, Min-Ah Woo, Hyun-Joo Chang, Nari Lee, and Min-Cheol Lim. 2023. "Biosynthesis of Silver Nanoparticles from Duchesnea indica Extracts Using Different Solvents and Their Antibacterial Activity" Microorganisms 11, no. 6: 1539. https://doi.org/10.3390/microorganisms11061539
APA StyleKim, S.-M., Choi, H.-J., Lim, J.-A., Woo, M.-A., Chang, H.-J., Lee, N., & Lim, M.-C. (2023). Biosynthesis of Silver Nanoparticles from Duchesnea indica Extracts Using Different Solvents and Their Antibacterial Activity. Microorganisms, 11(6), 1539. https://doi.org/10.3390/microorganisms11061539

